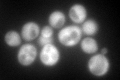
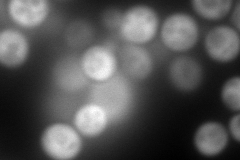
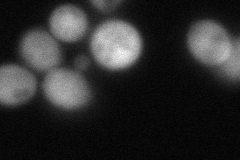
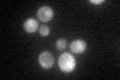

View description
Aromatic aminotransferase I, expression is regulated by general control of amino acid biosynthesis
Localization:
Intensity:
Fold change:
Significance:
-
C’ GFP library in SD
cytosol218.62 -
N' NOP1pr-GFP in SD

cytosol443.169 -
N' TEF2pr-mCherry in SD
cytosol506.781 -
N' NATIVEpr-GFP in SD

cytosol98.6687 -
N' TEF2pr-VC and Cyto-VN in SD
cytosol81.4567 -
C’ GFP library in SD+DTT

cytosol179.020.81No -
C’ GFP library in SD+H2O2

cytosol198.480.9No -
C’ GFP library in Starvation Media
nucleusN/AN/AYes -
C’ GFP library on the background of Pup2-DaMP

cytosol -
C’ GFP library on the background of CCT mutant

cytosol225.8221.0329No
